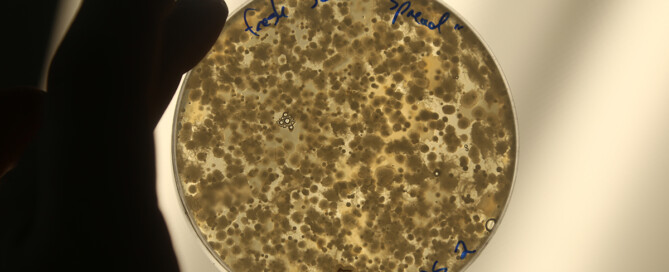

Categoría vertical primaria
Los productos fertilizantes Huma Gro® aumentan el rendimiento de los pepinos con una rentabilidad del 113%.
El tratamiento fertilizante Huma Gro® aumentó el rendimiento del pepino en un 2% (8 fanegas por acre) respecto al Cheque, con un retorno de la inversión (ROI) del 113%.